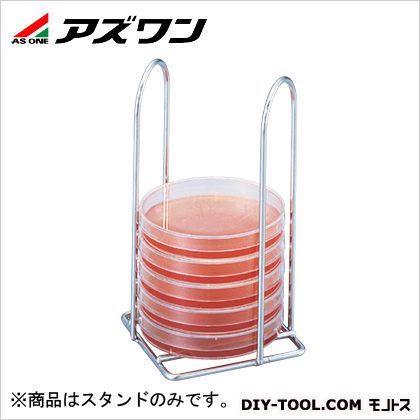
シャーレスタンド 6枚収納 φ75サス 92×92×165mm 3-468-04 1個

111ページ目: アズワン
-
電動工具・空圧工具 (55)

-
作業工具 (171)

-
切削工具・研磨材 (51)

-
測定・計測用品 (895)

-
安全用品・保護具 (984)

-
物流・保管・梱包用品・機械部品 (545)

-
塗料・塗装内装用品・接着補修材・テープ (151)

-
はんだ.溶接用品・静電気対策・スプレー・オイル (194)

-
水廻り部材・配管・空圧油圧機器 (328)

-
建築金物・建材・住宅設備 (29)

-
空調電設資材・照明器具 (25)

-
ねじ・釘・ボルト・素材 (157)

-
事務用品・文房具・PC用品 (161)

-
清掃用品 (307)

-
オフィス家具・家電・季節用品 (286)

-
ガーデニング用品・園芸資材 (12)

-
日用品・サニタリー用品・調理用品 (51,193)

- ブランド: アズワン
- すべて解除する
-
7,390円 (税込)2営業日1種類の商品があります2営業日
-
19,900円 (税込)2営業日1種類の商品があります2営業日
-
7,390円 (税込)2営業日1種類の商品があります2営業日
-
66,900円 (税込)2営業日1種類の商品があります2営業日
-
5,090円 (税込)2営業日1種類の商品があります2営業日
-
3,190円 (税込)2営業日1種類の商品があります2営業日
-
52,900円 (税込)2営業日1種類の商品があります2営業日
-
6,190円 (税込)2営業日1種類の商品があります2営業日
-
3,090円 (税込)2営業日1種類の商品があります2営業日
-
40,900円 (税込)2営業日1種類の商品があります2営業日
-
23,900円 (税込)2営業日1種類の商品があります2営業日
-
7,590円 (税込)2営業日1種類の商品があります2営業日
-
15,900円 (税込)2営業日1種類の商品があります2営業日
-
58,900円 (税込)2営業日1種類の商品があります2営業日
-
449円 (税込)2営業日1種類の商品があります2営業日
-
59,900円 (税込)2営業日1種類の商品があります2営業日
-
11,900円 (税込)2営業日1種類の商品があります2営業日
-
109,000円 (税込)2営業日1種類の商品があります2営業日
-
2,990円 (税込)2営業日1種類の商品があります2営業日
-
26,900円 (税込)4営業日1種類の商品があります4営業日
-
38,900円 (税込)2営業日1種類の商品があります2営業日
-
アズワン PETスクリューバイアル 60ml 1-9630-16 50本7,390円 (税込)
アズワン PETスクリューバイアル 60ml 1-9630-16 50本●中栓・パッキン無しでも液漏れを防止します。 アズワン PETスクリューバイアル 60ml 1-9630-16 50本の特徴●材質:本体/PET(ポリエチレン テレフタレート)、 キャップ/PP(ポリプロピレン)●容量(mL):60●口内径×胴径×全高(mm):φ28.5×φ40×76●入数:1箱(50本入)●型番:JST-R/N60 アズワン PETスクリューバイアル 60ml 1-9630-16 50本の仕様サイズ60ml1963016 __snahost = "r3.snva.jp"; recoConstructer( } }); ...
7,390円 (税込)2営業日1種類の商品があります -
アズワン アズピュア抗菌粘着マット6090(中粘着) 600×900 6シート 1-3933-72 119,900円 (税込)
アズワン アズピュア抗菌粘着マット6090(中粘着) 600×900 6シート 1-3933-72●水溶性粘着剤を使用した抗菌仕様です。●埃やゴミを嫌う作業現場で、入室前に靴底の汚れを取り除きます。●タグはフィルムをめくると数字が減るカウントダウン式です。アズワン アズピュア抗菌粘着マット6090(中粘着) 600×900 6シート 1-3933-72の特徴●材質:MDPE(中密度ポリエチレン)●水溶性粘着剤(抗菌仕様)●厚み:35μm/層(フィルム)●通し番号付き(カウントダウン)●サイズ(mm):600×900●型番:6090●入数:1箱(30層/シート×6シート)●中粘着タイプ●特注可能1393372 __snahost = "r3.snva.jp"; recoConstructer( } }); ...
19,900円 (税込)2営業日1種類の商品があります -
アズワン 耐久ラインテープ(プラコア) オレンジ 1-2604-07 17,390円 (税込)
アズワン 耐久ラインテープ(プラコア) オレンジ 1-2604-07●耐熱・耐薬性のある丈夫なラインテープ。●耐熱性・耐薬品性・耐久性・耐紫外線性に優れ、変色・変形しにくく光沢を長時間維持します。●油性マジック等の頑固な汚れも拭き取るだけ アズワン 耐久ラインテープ(プラコア) オレンジ 1-2604-07の特徴●材質:本体/PET(ポリエチレンテレフタレート)フィルム+特殊コート、芯/プラスチック●厚み:0.16mm●不燃性●抗菌・防カビ加工済●幅×長さ:50mm×20m●入数:1巻●プラコア●色:オレンジ1260407 __snahost = "r3.snva.jp"; recoConstructer( } }); ...
7,390円 (税込)2営業日1種類の商品があります -
アズワン 工業用内視鏡 3-6125-01 13,690円~ (税込)
アズワン 工業用内視鏡 3-6125-01●プローブは155°可動で、エンジンオイル・航空燃料・タービンオイル等に耐性があります。●画像回転機能により、文字の読み取りが容易にできます。●ダストフリー機能により、水滴や アズワン 工業用内視鏡 3-6125-01の特徴●型番:F300-6.0mm1m articulation Hyperion probe●解像度:640×480ピクセル●保存形式:JPEG・AVI●焦点距離:10~60mm●機能:ブースト・画像回転・反射防止・ダストフリー●電源:単3乾電池×4本(テスト用付属)●防塵・防水:本体/IP55、カメラケーブル/IP67(操作部・接合部は除く)●サイズ:本体/116×140×42mm、プローブ/φ6mm×1m●重量:本体/約300g、プローブ/約200g●付属品:クランプ(本体固定用)、SDカード(4GB)●※医療用途にはご使用できません。3612501 __snahost = "r3.snva.jp"; recoConstructer( } }); ...
-
アズワン PCR用チューブ 0.2ml 2-6672-02 1000本10,900円~ (税込)
アズワン PCR用チューブ 2-6672-06型番:3247-00仕様:リアルタイムPCR用8連チューブアズワン PCR用チューブ 2-6672-06の仕様 サイズ0.2ml2667206__snahost = "r3.snva.jp";recoConstructer( }}); __snahost = "r3.snva.jp"; recoConstructer( } }); ...
-
アズワン トラップボトル66,900円 (税込)
アズワン トラップボトル 2-7593-11型番:F19917-0001アズワン トラップボトル 2-7593-11の仕様 サイズ1.6L 重量620g2759311 __snahost = "r3.snva.jp"; recoConstructer( } }); ...
66,900円 (税込)2営業日1種類の商品があります -
5,090円 (税込)2営業日1種類の商品があります
-
アズワン 結晶皿 1-4403-01 1個3,190円~ (税込)
アズワン 結晶皿 1-4403-02直径×高さ(mm):φ120×601440302__snahost = "r3.snva.jp";recoConstructer( }}); __snahost = "r3.snva.jp"; recoConstructer( } }); ...
-
アズワン デュワーフラスコ(浅型)[SCH15] 5-390-02 152,900円~ (税込)
A(φmm):170B(φmm):205C(φmm):215D(mm):110E(mm):160仕様●材質:ボロシリケートガラス●液体窒素使用可能(メーカー) アズワン株式会社539004 __snahost = "r3.snva.jp"; recoConstructer( } }); ...
-
アズワン ハサミ反セン刀両鈍 横はずし No.9 145mm 2-535-12 1本5,990円~ (税込)
特徴仕様: ●材質:ステンレス(SUS420-J2) ●型番:No.9 ●全長(mm):145 ●タイプ:横はずし ●SCISSORS仕様サイズ145mm入数1本No9...
-
アズワン ナビシーツ II(デニム防水タイプ) デニムブルー3,190円 (税込)
アズワン ナビシーツ II(デニム防水タイプ) デニムブルー 0-1531-11●ベッド巻き込み部は両サイドにたっぷりありますので、抜け落ちがありません。●やさしい肌触りで色落ちが少ないデニム生地です。●裏面の防水部分に強力な圧着を施しているので剥離しにくいです。アズワン ナビシーツ II(デニム防水タイプ) デニムブルー 0-1531-11の特徴●型番:デニムブルー●幅×長さ(mm):1750×900●材質:表地/デニム・ ツイル生地(綿35%・ ポリエステル65%)、裏地/耐熱PU(ポリウレタン)●洗濯方法:洗濯可/脱水機可/乾燥機可(130℃以下)0153111 __snahost = "r3.snva.jp"; recoConstructer( } }); ...
3,190円 (税込)2営業日1種類の商品があります -
アズワン ナビキャッチ (フタ付き) (クリーム) 0-2227-11 1639円~ (税込)
アズワン ナビキャッチ (フタ付き) (クリーム) 0-2227-11●カップの曲線が頭部に密着し、寝たままの状態でも容易に使用できます。●付属のフタで嘔吐物や排液の中身が見えず、臭いを外に逃がしません。アズワン ナビキャッチ (フタ付き) (クリーム) 0-2227-11の特徴●材質:PP(ポリプロピレン)●容量:950mL●重量:130g(フタ含む)●オートクレーブ可(121℃)●色:クリーム●幅×奥行×高さ(mm):198×115×88●入数:1個入●型番:CA-C0222711 __snahost = "r3.snva.jp"; recoConstructer( } }); ...
-
アズワン ナビスメイトワゴン(天板木目タイプ)引出付 458×406×867mm 0-4147-02 152,900円 (税込)
アズワン ナビスメイトワゴン(天板木目タイプ)引出付 458×406×867mm 0-4147-02●見ても、触れても温もりある木目調。●院内環境に合う、やさしくぬくもりを感じさせる木目調です。●天板の傷や汚れが目立ちにくく、長く清潔感が保てます。アズワン ナビスメイトワゴン(天板木目タイプ)引出付 458×406×867mm 0-4147-02の特徴●材質:本体・ 引出し/ステンレス(SUS304)、天板/ABS樹脂、仕切板/PET樹脂●引出し内寸:335×325×100mm●棚間隔:325mm●キャスター:φ100mm(ストッパー無し)●重量:9.4kg●耐荷重:約20kg●引出し落下防止ストッパー付き●足パイプ径:φ25mm●幅×奥行×高さ(mm):458×406×867●※仕切板は付属していません。●木目タイプ●型番:NM-4(引出し付き)0414702 __snahost = "r3.snva.jp"; recoConstructer( } }); ...
52,900円 (税込)2営業日1種類の商品があります -
アズワン クライオチューブインナーキャップ[363401] 48×12.5mm 2-5479-05 10包26,900円~ (税込)
規格(mm):70×12.5容量@改行(ml):4使用容量@改行(ml):3.6特長●広範な冷却システムに適しています。 ●別売のクライオカラーコードを使用すると識別に便利です。 ●開閉自在のジップロック包装になっています。仕様●材質:PP(ポリプロピレン)●1包入数:100個●無毒性、パイロジェンフリー●電子線滅菌済 ●CEマーク取得・ISO11137承認(滅菌加工 SAL10-6)(メーカー) アズワン株式会社2547910 __snahost = "r3.snva.jp"; recoConstructer( } }); ...
-
アズワン ダストクリーナー 3点セット(CO2) 8-523-01 1個7,190円~ (税込)
アズワン ダストクリーナーKHR-A01-BF 2-9702-12 5枚 アズワン ダストクリーナーKHR-A01-BF 2-9702-12 5枚の特徴●パックフィルタ1袋(5枚入)●型番:KHR-A01-BF2970212 __snahost = "r3.snva.jp"; recoConstructer( } }); ...
-
アズワン フィルターハウジング3,590円~ (税込)
接続口径:PT1/4サイズ(mm):φ115×302特長●250mmのカートリッジフィルター用のハウジングで、活性炭や糸巻きフィルター、プリーツフィルター等が入ります。仕様●材質:キャップ/PP(ポリプロピレン)、透明ケース/スチレンアクリロニトリル●PT1/4×外径φ6mmホースニップル×2個●使用水温:2~40℃ ●保証圧力:5kgf/cm2まで(メーカー) アズワン株式会社1574002__snahost = "r3.snva.jp";recoConstructer( }}); __snahost = "r3.snva.jp"; recoConstructer( } }); ...
-
アズワン ヨーチンブラシ 30×220mm 0-084-11 1個879円~ (税込)
特徴●型番:No.30●幅×全長(mm):30×220●毛丈(mm):28●材質:毛/羊毛(ヤギ毛)、ハンドル/木仕様サイズ30×220mm入数1個008411...
-
6,190円 (税込)2営業日1種類の商品があります
-
アズワン 体位固定補助クッション800mm用替えカバー 0-6246-11 1個3,390円~ (税込)
特徴●材質:綿70%・ポリエステル30%●洗濯方法:洗濯可/脱水不可/乾燥機可●800用替えカバー●型番:DPC-111-800仕様入数1個0624611...
-
アズワン スリムステッキ 0-9263-02 1個5,490円~ (税込)
特徴●材質:シャフト/軽量アルミニウム、グリップ/天然木●全長:740~840mm(25mm間隔・4段階調節)●折りたたみ時サイズ:約29cm●シャフト先端部径:φ16mm●重量:270g●付属品:予備先端ゴム・携帯ケース●色:ロイヤルブラウン●型番:0401-SO5815仕様入数1個0926301...
-
アズワン テフロン(R)撹拌シール 7-066-01 111,900円~ (税込)
仕様:24/32●材質:テフロン(R)(PTFE)(メーカー) アズワン株式会社706601__snahost = "r3.snva.jp";recoConstructer( }}); __snahost = "r3.snva.jp"; recoConstructer( } }); ...
-
アズワン 静音樹脂運搬車 900×600×995mm 1-5530-01 111,900円~ (税込)
特徴特徴:●静音キャスターを採用した樹脂台車です。●フットブレーキ付です。 仕様:●型番:SPC150FB●耐荷重(kg):150●サイズ(mm):708×452×885●重量(kg):10.9●材質:本体/PP(ポリプロピレン)、キャスター/ゴム●キャスター(2輪自在、2輪固定):Φ100mm仕様サイズ708×452×885入数1個3656401...
-
アズワン プラスチック透明眼帯[アイカバー] 8-7575-0111,900円~ (税込)
特徴●滅菌・ひも付き●入数:1枚/袋×30袋入●材質:カップ部/PC(ポリカーボネート)、ひも/ポリエステル・綿、ひも留め/PS(ポリスチレン)●カップ部サイズ:77×57mm●重量:10g●EOG滅菌済(個包装)●型番:8928-01仕様入数30袋8757502...
-
アズワン ディスポ耐水ベッドシーツ3,090円 (税込)
特徴●型番:KW138081●サイズ(mm):810×1380●材質:表面/PE(ポリエチレン)コート不織布、裏面/PP(ポリプロピレン)布織布(スパンボンド)●入数:1袋(10枚入)●防水加工●巻き込み型仕様サイズ810×1380mm入数10枚0814201...
3,090円 (税込)2営業日1種類の商品があります -
アズワン PH510,1100電極EC620131 1-6938-22 140,900円 (税込)
型 番/EC-620-131測定項目/交換用pH電極(メーカー) アズワン株式会社1693822 __snahost = "r3.snva.jp"; recoConstructer( } }); ...
40,900円 (税込)2営業日1種類の商品があります -
アズワン PH310用電極ECFC7352901W 1-5416-12 123,900円 (税込)
型 番/EC-FC73529-01W測定項目/交換用専用pH電極(3イン1型)(メーカー) アズワン株式会社1541612 __snahost = "r3.snva.jp"; recoConstructer( } }); ...
23,900円 (税込)2営業日1種類の商品があります -
アズワン センターリング 1-2103-01 14,190円~ (税込)
アズワン センターリング 1-2103-01型番:SCK-2016フランジ:KF-16A:17B:16C:3.9D:8掲載分類名大:汎用機器掲載分類名中:液送・加圧・減圧ポンプアズワン センターリング 1-2103-01の仕様 材質リング/ステンレス(SUS304)、Oリング/バイトン1210301__snahost = "r3.snva.jp";recoConstructer( }}); __snahost = "r3.snva.jp"; recoConstructer( } }); ...
-
アズワン 吸気アダプターKF25吸気アダプター 1-2104-02 17,590円 (税込)
アズワン 吸気アダプター KF25吸気アダプター 1-2104-02型番:KF25吸気アダプター規格:KF25×M20×P1掲載分類名大:汎用機器掲載分類名中:液送・加圧・減圧ポンプ特長●KF-25の吸気管をM20に変換するためのアダプタです。●KF-25吸気アダプタはKF-25吸気管機種に適用し、標準吸気管を取り外さずに取り付けることができます。適合機種●GLD-136A/C・201A/B、GCD-051X・136X・201Xアズワン 吸気アダプター KF25吸気アダプター 1-2104-02の仕様 重量200g 材質アルミニウム1210402 __snahost = "r3.snva.jp"; recoConstructer( } }); ...
7,590円 (税込)2営業日1種類の商品があります -
アズワン スライドガラス 1-9646-12 100枚939円~ (税込)
アズワン スライドガラス (1-9646-12) 1箱(100枚入)アズワン スライドガラス (1-9646-12)仕様 材質 ソーダガラス サイズ(幅×長さ) 25.4×76.2mm フロストサイズサイズ 20mm 1964612__snahost = "r3.snva.jp";recoConstructer( }}); __snahost = "r3.snva.jp"; recoConstructer( } }); ...
-
アズワン サーモピット 1KC150 2-2601-19 12,590円~ (税込)
●設定温度に達した履歴を残します食品添加物に認定されている石油系天然ワックスの物性変化を利用しており、鉛・水銀・クロム等環境負荷物質を含まず、安全性が高いです。●型番:3IC 140●10℃間隔●精度:±2℃●ベース部色:白色●メーカー屋外曝露促進試験10年クリアー●入数:1箱(20枚入)●発色温度:140・150・160℃●発色色調:白→黒●タイプ:化学変化●不可逆性・3温表示●※保管方法:発色温度より-20℃程度の冷暗所で保管してください。...
-
アズワン サンプル採取用バッグスタンドBG-SA15,900円 (税込)
アズワン サンプル採取用バッグスタンドBG-SA 2-4215-01●1台2役のバッグスタンド。●電子天秤に載せての秤量と、ストマフィルター袋から液体を採取しやすくすることができる1台2役のバッグスタンドです。アズワン サンプル採取用バッグスタンドBG-SA 2-4215-01の特徴●材質:PVC(上部粘着シール付)、粘着シール/PU(ポリウレタン)・ ポリエステル、脚部/発泡スチレン●重量:約600g●サイズ(mm):220×180×245●入数:1個●※総重量がご使用の天秤で秤量可能かご確認ください。●型番:BG-SA2421501 __snahost = "r3.snva.jp"; recoConstructer( } }); ...
15,900円 (税込)2営業日1種類の商品があります -
アズワン ミニ撹拌機 MS-1N58,900円 (税込)
アズワン ミニ撹拌機 MS-1N 2-7835-11●スタンド不要で、容易に使用できます。●ビーカーに被せて使用しますのでビーカーへの羽根の出し入れが容易です。アズワン ミニ撹拌機 MS-1N 2-7835-11の特徴●モーター出力:高回転DCブラシモーター(約18W)●対応ビーカー:高さ160mm以下●安全装置:モーター過電流防止スイッチ●材質:外装/亜鉛ダイキャスト+焼付塗装、脚部/POM(ポリアセタール)、羽根及び軸/ステンレス(SUS304)●サイズ:全高/115×230×230mm、本体下面までの高さ/170mm●電源:AC100V~240V50/60Hz(専用ACアダプタ付属)●電源コード長:2.1m(3Pプラグ)●重量:2.5kg●回転数(rpm):0~2500●型番:MS-1N2783511 __snahost = "r3.snva.jp"; recoConstructer( } }); ...
58,900円 (税込)2営業日1種類の商品があります -
アズワン トレイBOX(鍵付)402H A4用ブルー 290×360×205mm 0-5347-13 17,390円~ (税込)
アズワン トレイBOX(鍵付)402H A4用ブルー 290×360×205mm 0-5347-13●鍵付きで、積み重ねることができます。●1つの鍵で全ての段数をロックできます。アズワン トレイBOX(鍵付)402H A4用ブルー 290×360×205mm 0-5347-13の特徴●材質:ABS樹脂●引出耐荷重:約7kg/段●タイプ:A4用●色:ブルー●引出:1個●幅×奥行×高さ(cm):29×36×20.5●鍵付●型番:402H0534713 __snahost = "r3.snva.jp"; recoConstructer( } }); ...
-
アズワン アルティア小物ユニット交換用樹脂ケース A4ケース・クリア 213×305×70mm 0-5975-01 11,190円~ (税込)
アズワン アルティア小物ユニット交換用樹脂ケース A4ケース・クリア 213×305×70mm 0-5975-01●保護スポンジを敷くことでアンプルなどのガラス品の保護が可能です。アズワン アルティア小物ユニット交換用樹脂ケース A4ケース・クリア 213×305×70mm 0-5975-01の特徴●材質:PS(ポリスチレン)●ケース内寸法:(幅)213×(奥行)305×(高さ)70mm●アンプル保護スポンジ:(幅)95×(長さ)300×(厚み)5mm●仕切板取り付け可能数:6枚●A4ケース・ クリアー●※仕切版は別売です。●型番:WB-20597501 __snahost = "r3.snva.jp"; recoConstructer( } }); ...
-
アズワン ヨーロピアンカート用ワイヤーホルダー インサートナット449円 (税込)
アズワン ヨーロピアンカート用ワイヤーホルダー インサートナット 0-7898-25●便利な回診車用バスケットです。用途に合わせてお選びください。●処置に必要な消耗品・ 院内感染防止品・ 備品類を収納できます。●サイドハンガーネットは各種ホルダーを掛けるだけでなく、S字フック等を取り付けることもできます。アズワン ヨーロピアンカート用ワイヤーホルダー インサートナット 0-7898-25の特徴●材質:サイドハンガーネット/スチールPE(ポリエチレン)コーティング、各種ホルダー/ステンレス(SUS304)●サイドハンガーネット耐荷重:3kg●サイドハンガーネット(0-7898-01)取り付け可能回診車サイズ:幅(奥行)450mm、パイプ径φ25mm●1袋(2個入)●※各種ホルダーを取り付ける際には、サイドハンガーネットが必要です。※ヨーロピアンカートやポータブルカートに各種ホルダーを取り付けるためには、インサートナットとサイドハンガーネットが必要です。※サイズはハンガー部を除きます。●型番:インサートナット0789825 __snahost = "r3.snva.jp"; recoConstructer( } }); ...
449円 (税込)2営業日1種類の商品があります -
アズワン ナビスメイトワゴン A3引出し青タイプ 補助天板無し 543×398×867mm 0-7920-01 159,900円 (税込)
アズワン ナビスメイトワゴン A3引出し青タイプ 補助天板無し 543×398×867mm 0-7920-01●天板とステンレスフレームの間に発泡ウレタンを敷き詰めていますので静音特性に優れています。●樹脂製の鍵付き引出しを2段装備していますので小物入れなどに便利です。アズワン ナビスメイトワゴン A3引出し青タイプ 補助天板無し 543×398×867mm 0-7920-01の特徴●材質:フレーム/ステンレス(SUS304)、天板/ABS樹脂、引出し/樹脂製●引出し(鍵付き):425×305×70mm×2段●サイズ:543×398×867mm●キャスター:φ100mm(ストッパー無し)●足パイプ径:φ25mm●重量:14.8kg●補助天板:無し●A3引出し青タイプ●※仕切板は付属していません。●トレイBOX●型番:NM-A304H0792001 __snahost = "r3.snva.jp"; recoConstructer( } }); ...
59,900円 (税込)2営業日1種類の商品があります -
アズワン SUS製ピペットラック 25本 MPR-25 4-1715-01 1個11,900円 (税込)
アズワン SUS製ピペットラック 25本 MPR-25 4-1715-01 1個●SUS製のピペットラックでオートクレーブでの滅菌が可能なため、清潔に使用可能です。●側面上側には各5ヶ所の切れ込みがあり、使用時の仮置きなどに便利です。●オートクレーブ可●収納本数:25本●サイズ(mm):112×110×200●材質:SUS304●穴径:上段/Φ17mm、下段/Φ5mm●オートクレーブ可特徴4171501...
11,900円 (税込)2営業日1種類の商品があります -
アズワン 水分活性測定装置 ログ記録可(999件) MD-AW3 4-2453-03 1台109,000円 (税込)
アズワン 水分活性測定装置 ログ記録可(999件) MD-AW3 4-2453-03 1台●卓上使いに便利な小型タイプでシンプル設計。現場での測定にも邪魔になりません。●サンプルカップをセット後、ボタン一つで測定できる簡単操作です。(約5分)●表示部と試料格納部が分かれており、安定感と作業性を向上させました。●時計機能を有しており、メモリ機能付きでは打刻を行います。●999件のメモリ記録が可能で、USBケーブルを利用し、記録したCSVファイルを取り出すことができます。●小型で便利、幅広いレンジで水分活性が測定できます。●タイプ:ログ記録可(999件)●本体サイズ(mm):120×60×58●本体材質:ステンレス(SUS304)●測定方式:静電容量式湿度センサー●測定範囲:0~1.00Aw●測定精度:±0.03Aw(0~0.9Aw)、 ±0.04Aw(0~0.9Aw以外) / 試料・周囲温度25℃時●分解能:0.01Aw●電源:単3乾電池×2本(テスト用付属)●付属品:サンプルカップ100枚(材質:PS/カップ内径φ35×10mm)、交換用フィルター3枚、USBケーブル1m(AW3のみ)●交換用シャーレ材質:PS●重量:0.6kg(電池含む)特徴4245303...
109,000円 (税込)2営業日1種類の商品があります -
2,990円 (税込)2営業日1種類の商品があります
-
アズワン 持手付アルミカップ 23ml 5-075-05 100本3,390円~ (税込)
アズワン 持手付アルミカップ 5-075-07型番:No.5上部径(下部径)×深さ(mm):φ76.5(φ70.5)×16掲載分類名大:容器類掲載分類名中:金属製容器アズワン 持手付アルミカップ 5-075-07の仕様 サイズ67ml507507__snahost = "r3.snva.jp";recoConstructer( }}); __snahost = "r3.snva.jp"; recoConstructer( } }); ...
-
アズワン ドライブロックバスブロック0.5mlマイクロチューブ用・49本架 1-7554-11 126,900円 (税込)
仕様:ブロック0.5mlマイクロチュ-ブ用・49本架(メーカー) アズワン株式会社1755411 __snahost = "r3.snva.jp"; recoConstructer( } }); ...
26,900円 (税込)4営業日1種類の商品があります -
アズワン アルミナるつぼ(ふた)100ml用 1-9787-03 12,390円~ (税込)
1978703 __snahost = "r3.snva.jp"; recoConstructer( } }); ...
-
アズワン ミドルハイトフード38,900円 (税込)
アズワン ミドルハイトフード 3-4064-37本体サイズ(mm):611×300×2253406437 __snahost = "r3.snva.jp"; recoConstructer( } }); ...
38,900円 (税込)2営業日1種類の商品があります -
アズワン TC-1用仕切板大 ブルー 1-9537-11 1439円~ (税込)
アズワン TC-1用仕切板 大 1-9537-11外寸法(mm):381×95×4.5tアズワン TC-1用仕切板 大 1-9537-11の仕様 カラーブルー1953711 __snahost = "r3.snva.jp"; recoConstructer( } }); ...
-
アズワン シャーレスタンド 6枚収納 φ75サス 92×92×165mm 3-468-04 1個2,390円~ (税込)
アズワン シャーレスタンド 6枚収納 φ90サス 3-468-05型番:φ90サスアズワン シャーレスタンド 6枚収納 φ90サス 3-468-05の仕様 サイズ105×105×165mm346805 __snahost = "r3.snva.jp"; recoConstructer( } }); ...
-
アズワン るつぼ(A型) (本体) 15ml 5-4046-01 1個709円~ (税込)
アズワン るつぼ(A型) (本体) 5-4046-01型番:CW-A0●化学組成:SiO2/63%、Al2O3/31%●耐熱温度:1050℃(常用)外径×高さ(mm):φ41×25※本体にフタは付属していません。アズワン るつぼ(A型) (本体) 5-4046-01の仕様 サイズ15ml5404601__snahost = "r3.snva.jp";recoConstructer( }}); __snahost = "r3.snva.jp"; recoConstructer( } }); ...
-
アズワン トートボックス 仕切板ヨコ 3-348-11 1枚1,590円~ (税込)
アズワン トートボックス 仕切板ヨコ 3-348-11型番:LD22334811 __snahost = "r3.snva.jp"; recoConstructer( } }); ...
55,544件(5281~5328件)









![デュワーフラスコ(浅型)[SCH15] 5-390-02 1](https://image.torano-te.jp/image_optimal/tuzukiya/cabinet/main/a28-18/a28-3769.jpg?v=20251220100228)





![クライオチューブインナーキャップ[363401] 48×12.5mm 2-5479-05 10包](https://image.torano-te.jp/image_optimal/tuzukiya/cabinet/0/1/334/a28-3119.jpg?v=20251220100211)








![プラスチック透明眼帯[アイカバー] 8-7575-01](https://image.torano-te.jp/image_optimal/tuzukiya/cabinet/0/1/141/a28-58196.jpg?v=20251220100324)